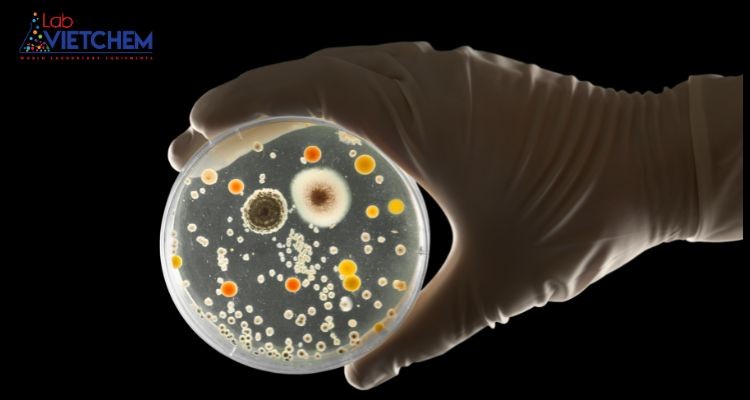
Thuộc địa
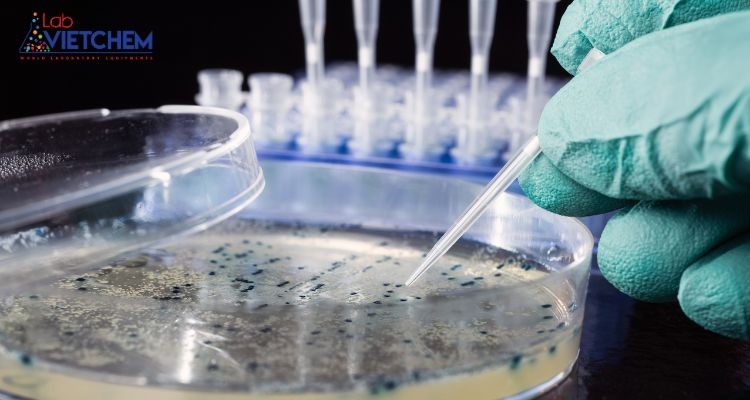
Văn hóa thuộc địa
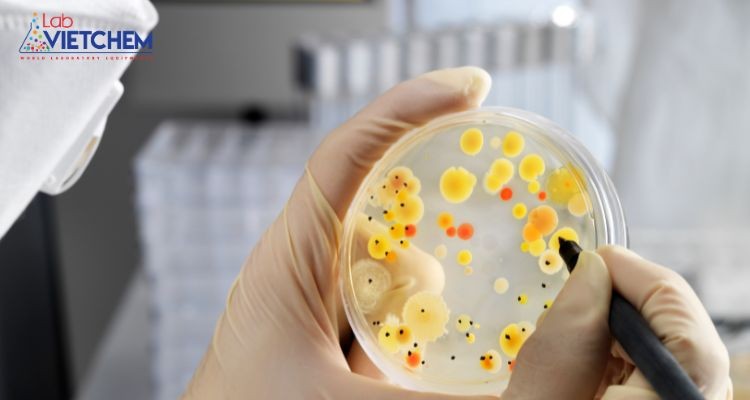
Đếm khuẩn lạc bằng tay

Nội dung bài viết
Thuộc địa là gì? Hình thái của thuộc địa là gì? Có bao nhiêu loại và phương pháp đếm khuẩn lạc là gì? Những câu hỏi trên sẽ được LabTrường Lê Hồng Phong giải đáp thông qua bài viết dưới đây.
1. Thuộc địa là gì?
Thuộc địa là tập hợp các vi khuẩn phát triển thành từng cụm (Colony) có thể nhìn thấy bằng mắt thường khi chúng phát triển trên bề mặt chất nền cứng.
Nói một cách đơn giản, khi chúng ta nuôi một số vi sinh vật nhất định trong môi trường nuôi cấy, chúng sẽ sinh trưởng và phát triển thành khuẩn lạc.
Thuộc địa
2. Hình thái của khuẩn lạc
Hình thái của khuẩn lạc rất đa dạng tùy thuộc vào loại vi khuẩn và điều kiện môi trường.
Quan sát dưới kính hiển vi, bạn sẽ thấy chúng có hình dạng và kích thước đồng đều, mọc thành từng cụm.
Các cụm vi khuẩn thường có đường kính từ vài micromet đến vài chục micromet.
Màu sắc của khuẩn lạc có thể khác nhau tùy thuộc vào loại vi khuẩn và điều kiện môi trường, thường có màu trắng hoặc vàng khi nhìn thấy dưới ánh sáng.
3. Đơn vị đếm khuẩn lạc
3.1. Đơn vị dạng thuộc địa – CFU
Đơn vị hình thành khuẩn lạc (CFU) là đơn vị tiêu chuẩn được sử dụng để ước tính số lượng tế bào vi khuẩn hoặc nấm trong một mẫu thử nghiệm cụ thể. Khi thực hiện kiểm tra vi sinh đối với mẫu thử, việc đếm khuẩn lạc trên đĩa Petri hoặc trên các đĩa môi trường đã chuẩn bị sẵn (như đĩa Compact Dry) được thực hiện. Kết quả đo có sẵn theo đơn vị CFU/mL, CFU/g hoặc CFU/25g.
Đơn vị CFU/g và CFU/25g thường được sử dụng cho các mẫu thử dạng rắn, chẳng hạn như thực phẩm và thành phần thực phẩm.
Trong khi đó, đơn vị CFU/mL thường được sử dụng cho các mẫu thử nghiệm ở dạng dung dịch, như mẫu nước nuôi trồng thủy sản, nước ép trái cây.
3.2. Con số có thể xảy ra nhất – MPN
MPN là viết tắt của Most Probable Number, hay có thể hiểu là “con số có xác suất lớn nhất”. MPN thường được sử dụng để đo số lượng vi khuẩn trong một thể tích nhất định của mẫu chất lỏng.
3.3. Sự khác biệt giữa CFU và MPN
CFU và MPN đều được nhiều tổ chức khoa học quốc tế công nhận, trong đó có Cơ quan Bảo vệ Môi trường Hoa Kỳ EPA và Tổ chức Tiêu chuẩn hóa Quốc tế ISO. Tùy theo phương pháp nuôi cấy mà sử dụng đơn vị đo lường thích hợp.
– CFU là đơn vị đo lường số lượng vi khuẩn hoặc vi sinh vật khác có trong một mẫu thử nghiệm nhất định. Thông thường, CFU được đếm bằng phương pháp đổ đĩa hoặc đổ đĩa, sau đó đếm số lượng đơn vị hình thành khuẩn lạc. Trong quá trình đếm CFU, vi khuẩn được phát triển trên môi trường rắn, chẳng hạn như thạch. Sau một thời gian sinh trưởng, các khuẩn lạc sẽ được đếm thủ công hoặc sử dụng công nghệ hiện đại.
– Ngược lại với CFU, phương pháp đo MPN ( Most Probable Number) thường được tính theo phương pháp lên men. Trong quá trình này, mẫu được trồng trên môi trường lỏng, chẳng hạn như môi trường lên men. Thay vì tính trực tiếp, kết quả MPN được xác định thông qua so sánh với bảng xác suất.
4. Các cách đếm khuẩn lạc phổ biến
4.1. Pha loãng, cấy và ủ mẫu
Trước khi đếm khuẩn lạc, cần pha loãng mẫu và nuôi cấy trên môi trường thạch. Bước này nhằm hạn chế tối đa tình trạng các khuẩn lạc riêng lẻ mọc chồng lên nhau, giảm thiểu sai sót và cho kết quả chính xác hơn.
Cách tiến hành: Pha loãng mẫu vi sinh với dung dịch sau đó tiếp tục trộn với dung dịch mẫu ban đầu. Làm điều này 6-10 lần. Tiếp theo, dàn đều dung dịch lên đĩa thạch và ủ. Sau thời gian ủ từ 4 đến 7 ngày, có thể đếm được số lượng khuẩn lạc phát triển.
Văn hóa thuộc địa
4.2. Phương pháp đếm khuẩn lạc thủ công
Quy trình đếm khuẩn lạc thường được thực hiện bằng cách đếm từng điểm khuẩn lạc một cách tuần tự. Một phương pháp phổ biến là sắp xếp các đĩa Petri thành một lưới và đếm số lượng khuẩn lạc trong mỗi ô của lưới. Đồng thời, đánh dấu các khuẩn lạc đã đếm được ở mặt sau đĩa Petri để tránh nhầm lẫn.
Để đảm bảo độ chính xác và giảm sai sót, hãy đếm ít nhất ba đĩa Petri. Đĩa Petri có số lượng khuẩn lạc dao động từ 30 đến 300 sẽ cho kết quả đáng tin cậy hơn. Còn đối với các đĩa petri có quá nhiều hoặc quá ít khuẩn lạc thì cần pha loãng và nuôi cấy lại để có kết quả chính xác hơn.
Đếm khuẩn lạc bằng tay
4.3. Phương pháp đếm khuẩn lạc tự động
Quá trình đếm khuẩn lạc thủ công mất nhiều thời gian và dễ gặp sai sót do yếu tố chủ quan của người thực hiện. Để khắc phục tình trạng này, chúng ta có thể sử dụng thiết bị đếm khuẩn lạc tự động.
Máy đếm khuẩn lạc tự động hoạt động bằng cách chụp ảnh đĩa chứa khuẩn lạc, sau đó tách các khuẩn lạc ra khỏi nền và sử dụng thuật toán để đếm chúng. Mặc dù điều này mang lại kết quả nhanh nhưng thuật toán có thể gặp khó khăn trong việc phân biệt các khuẩn lạc trong trường hợp hai hoặc nhiều khuẩn lạc chồng lên nhau ở mép đĩa.
Chúng tôi hy vọng những kiến thức được LabTrường Lê Hồng Phong chia sẻ trên đây sẽ giúp bạn đọc hiểu thêm về khuẩn lạc và tìm được phương pháp đếm khuẩn lạc phù hợp. Nếu bạn đọc có nhu cầu mua đĩa peptri hoặc môi trường nuôi cấy khuẩn lạc hãy liên hệ ngay với chúng tôi để được tư vấn miễn phí.
>> Xem thêm:
Vi sinh vật cần loại môi trường nuôi cấy nào?
Tổng hợp các phương pháp nuôi cấy vi sinh vật hiện nay

Nội dung được phát triển bởi đội ngũ truongchuvananhue.edu.vn với mục đích chia sẻ và tăng trải nghiệm khách hàng. Mọi ý kiến đóng góp xin vui lòng liên hệ tổng đài chăm sóc: 1900 0000 hoặc email: hotro@truongchuvananhue.edu.vn